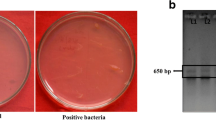

Abstract
In the present study halotolerant bacteria were isolated from saline soil (EC ~ 11.9). Based on salt tolerance and plant growth promoting characteristics isolate AF7 was selected for further study. It was identified as Alcaligenes sp. on the basis of protein profiling and 16S rRNA sequence homology. Interestingly, AF7 showed diverse PGP characters at different salinity levels. While phosphate solubilization activity was expressed up to 300 mM NaCl, siderophore production was shown up to 700 mM, zinc solubilization up to 1000 mM and indole acetic acid (IAA), gibberellic acid (GA) and exopolysaccharides (EPS) production were depicted till 1400 mM. Correlative and regression analysis suggested positive relation between IAA, GA, EPS, siderophore production and zinc solubilization capability of AF7 and salinity up to 300 mM NaCl. EPS was found to be the most significant response and there was 263% increment in presence of 300 mM NaCl when compared to non-saline control. Analysis also showed that while growth promoting attributes were significant up to a threshold salinity level, further increasing the stress deviates the mechanism towards survival involving proline, antioxidant and hydroxyl scavenging activities. Combination of halotolerant AF7 and EPS showed more than twofold increase in the vegetative growth parameters of rice at ~ 170 mM NaCl (EC 9 dS/m). The study shows the mechanisms/metabolites of the plant growth promoting bacterium (PGPB) AF7 prominently involved during the salinity stress. Study also proves that novel bioformulations can be developed by integrative use of EPS and salt tolerant-PGPB which can be effective for saline soils.
Similar content being viewed by others
Explore related subjects
Discover the latest articles, news and stories from top researchers in related subjects.Avoid common mistakes on your manuscript.
Introduction
Soil salinity is a global menace which has challenged the food security and has affected the agricultural sustainability. Soil salinization is the second leading cause of land degradation and desertification (only after soil erosion) affecting several countries across the globe (Orhan 2016). Currently, almost 1 billion hectares of land on Earth is degraded due to salinity (FAO 2015). Arora et al. (2018) highlighted the direct relationship between anthropogenic activities and increase in saline lands. Saline soils are characterized with electrical conductivity (ECe) greater than 4 dS/m at 25 °C and excess of accumulated salts of Na+, Ca+2, Mg+2, Cl−1, SO4−2, CO3−2 (Shahid et al. 2018). Salinity negatively impacts the physical structure and nutrient status of soil and thereby the growth and productivity of crops. The presence of high salt concentration restricts the uptake of minerals, nutrients, and water (Machado and Serralheiro 2017). Plant physiology is also impacted by salt toxicity resulting in reduced photosynthesis rate, lower germination and growth rate along with impaired yield. The hyperosmotic conditions cause loss of water in plant cell sap, and subsequent ionic imbalance results in reduction of enzyme activities, disrupted membrane structure and cell plasmolysis (Munns and Tester 2008; Rahneshan et al. 2018).
Physical and chemical methods to remediate saline soil require high energy input, are cost ineffective and unsustainable for the environment and agro-ecosystems (Osman 2018). Therefore, a green solution such as using beneficial soil microbes is emerging as cheap and eco-friendly remediation technique which can uplift the growth and productivity of salt-stressed habitats (Bargaz et al. 2018). Plant growth promoting bacteria (PGPB) are beneficial soil microbes that have the ability to form symbiotic association with plants, increasing their growth both under biotic and abiotic stresses (Fatima and Arora 2019; Rodriguez et al. 2019). The application of salt tolerant plant growth promoting bacteria (ST-PGPB) can help to mitigate the salt toxicity in plants through various mechanisms, involving osmotic adjustments via Na+ accumulation kinetics, endogenous biosynthesis of osmolytes, scavenging of reactive oxygen species (ROS) through antioxidant system and production of exopolysaccharides (EPS). ST-PGPB can also stimulate the growth of plants through production of phytohormones, siderophores and solubilization of phosphate, zinc (Zn) and potassium even under saline conditions (Etesami and Glick 2020).
Rice (Oryza sativa L) is the second most dominating crop of the world (after wheat) with 90% of cultivation area in Asia (Ghosh et al. 2016). India is the second largest producer of rice (after China). Additionally, for more than half of world’s population rice is considered as a staple food (Zeigler and Barclay 2008; https://www.worldatlas.com/articles/the-countries-producing-the-most-rice-in-the-world.html). Rice is a salt sensitive crop and electrical conductivity (EC) as low as 3.5 dS/m can lead to loss of about 10%, while 7.2 dS/m causes up to 50% reduction in yield (Umali 1993; Hoang et al. 2016). In the present study a plant growth promoting (PGP) bacterial isolate from saline soil was checked for its potential to tackle salinity. The PGP properties [of the halotolerant (HT) isolate] and mechanisms/metabolites working at high salinity were determined. ST-PGPB and its metabolite were utilized to develop bioformulation so as to combat salinity stress and enhance the growth of rice plants under the abiotic trauma.
Materials and methods
Isolation and identification of bacteria
Bacteria were isolated from the degraded saline soils (EC ~ 11.9 dS/m) collected from Kanpur Dehat region, 20°38 E and 80°21 N in central Uttar Pradesh, India, by serial dilution method on nutrient agar (NA) medium (Hi-Media). Isolates were grown on NA and maintained on 25% (w/v) glycerol at – 80 °C. In total, twelve isolates were tested for morphological, physiological, and biochemical characters according to Bergey’s Manual of Systematic Bacteriology (Garrity 2005). On the basis of salt tolerance isolate AF7 was selected for further study. Identification of the isolate AF7 was done by matrix-assisted laser desorption ionization time of flight mass spectrometry (MALDI-TOF-MS) at National Centre for Microbial Resources, Pune, India. The MALDI biotyper software 3.0 (Bruker Daltonik GmbH, Germany) was used to identify the isolate and visualize the mass spectra. The obtained log value if is ≥ 1.7 then the strains are confirmed as the member of that genus and if log value is ≥ 2.0 are confirmed as the member of that species (Rahi et al. 2016). Further the molecular analysis of bacteria was done by sequencing of 1.5 kb 16S rRNA sequences using the universal primers 27F 5′-AGAGTTTGATCMTGGCTCAG-3′ and 1492R 5′-GGTTACCTTGTTACGACTT-3′. PCR conditions were maintained as: initial denaturation 2 min at 95 °C, then one cycle denaturation 30 s at 95 °C, annealing 30 s at 52 °C, extension 2 min at 72 °C and final extension 15 min at 72 °C (Srinivasan et al. 2015). National Center for Biotechnology Information (NCBI)-BLASTn programme (Altschul et al. 1990) and Ez-Taxon server (Yoon et al. 2017) were used to analyze the sequences. Phylogenetic tree was constructed using neighbor-joining method (Saitou and Nei 1987) in MEGA X software (6.0 version) (Kumar et al. 2018). The isolate AF7 was also deposited at National Agriculturally Important Microbial Culture Collection (NAIMCC), National Bureau of Agriculturally Important Microorganisms (ICAR-NBAIM), India, a national culture repository.
Salt tolerance assay
The log phase culture of AF7 (OD 610 = 0.1) was added to nutrient broth amended with different concentrations of NaCl (0–1400 mM) and incubated for 48 h at 27 °C (120 rpm). Samples were drawn after every four hours and optical density was measured (at 610 nm) using Thermo Scientific™ Evolution 201 UV–Vis spectrophotometer up to stationary phase (Khare et al. 2011). The experiment was conducted in triplicates.
Plant growth promoting properties
To check the plant growth promoting properties, the log phase culture (24 h) of AF7 (with OD 610 = 0.1 CFU 108/ml) was added to respective medium containing different salt concentrations (300–1400 mM NaCl) and non-saline control was also maintained. Cell free supernatants were obtained by centrifugation at 10,000 rpm (13,081 × g) (21 °C) followed by membrane filtration (0.45 µm, Merk, India) (Khare et al. 2011). Phosphate solubilization was evaluated using Pikovskaya medium and solubilization index was calculated (Pikovskaya 1948). Zn solubilization property of the isolate was calculated through plate assay on Zn medium (dextrose, 1%; ammonium sulphate, 0.1%; potassium chloride, 0.02%; di-potassium phosphate, 0.01%; magnesium sulphate, 0.02%; Zn oxide, 0.1%; agar, 2%) (Fasim et al. 2002). GA was quantified according to Paleg (1965) and value was calculated from the standard graph of GA (100–1000 µg/ml). Quantitative production of IAA was determined using colorimetric method of Ahmad et al. (2008) on minimal broth containing L-tryptophan (200 µg/ml). Value was calculated from the standard graph of IAA (concentration 10–100 µg/ml). Siderophore production by the isolate was tested on Chrome-Azurol S (CAS) agar plates and CAS broth (using microtiter plates) (Schwyn and Neilands 1987; Arora and Verma 2017). Extraction of EPS was done according to the method of Mody et al. (1989). Bacterial culture was added to nutrient broth (with and without NaCl) and grown for 48 h at 200 rpm and 27 °C. After incubation cell debris and proteins were removed by centrifugation (7000 rpm at 4 °C) for 20 min. EPS was extracted by adding chilled acetone (1:3) to the supernatant and then separated by centrifugation (7000 rpm at 4 °C for 20 min). The precipitate of EPS obtained was washed with distilled water and re-precipitated using acetone, followed by drying at 40 °C. Purification of EPS was done through dialysis using dialysis bag (12 to 14 kDa) against distilled water at 4 °C for 48 h. EPS was collected by drying at 35 °C for 24 h and weight in g/100 ml was calculated (Mendi and Aslim 2014). Quantification of sugars in EPS was done using phenol–sulphuric acid method taking D-glucose as standard (Dubois et al. 1956). All the experiments were performed in triplicates and were statistically analyzed.
Salt tolerance properties of the isolate
Estimation of intracellular sodium ion accumulation in bacteria
The intracellular level of Na+ ions in the bacterial biomass was estimated according to Giri et al. (2013). Log phase (24 h) culture of the isolate AF7 (with OD610 = 0.1) was inoculated in medium with various NaCl concentrations (300–1400 mM) for 48 h. Samples were withdrawn after incubation and cell biomass was collected by centrifugation (at 3000 g). Furthermore, the cell pellets were washed thrice with isotonic MgCl2 solution (10 mM) and lysed by 30% HNO3. Intracellular Na+ was measured using flame photometer and the curve was plotted.
Endogenous accumulation of osmoprotectant proline in bacterial cells
The bacterial culture obtained from broth inoculated with log phase culture (as mentioned above) of different salinities (300–1400 mM) and control (0.5 ml) was homogenized with 2 ml of sulphosalicylic acid (0.01 g/0.5 ml) and centrifuged at 20,000 g for 10 min. The protein content of the culture was measured using the standard method of Bradford (1976). To 1 ml of the homogenized cells, 1 ml acid-ninhydrin reagent and 1 ml glacial acetic acid was added and heated at 100 °C in water bath for 1 h and finally reaction terminated in ice-bath. This mixture was then extracted with 2 ml toluene, mixed vigorously and incubated for 30 min at room temperature. After incubation two phases were separated, the chromophore containing phase was warmed at room temperature and the optical density was measured at 520 nm using toluene as blank. The amount was estimated from standard curve using D-proline and value expressed as µg/mg of protein (Bates et al. 1973).
Reducing power
Ferric reducing power of the isolate AF7 at various saline conditions was checked according to Xing et al. (2015). The supernatant (0.5 ml) of log phase bacterial culture with OD610 adjusted to ~ 0.1 was mixed with 0.5 ml of 1% potassium ferricyanide solution and 0.5 ml phosphate buffer saline (pH 6.6). This mixture was then heated at 50 °C for 20 min and allowed to cool. After cooling, 0.5 ml of trichloroacetic acid (TCA) (10%) was added and then centrifuged at 3000 g for 5 min. The upper layer was mixed with ferric chloride (0.1%, 1 ml) and made to react for 1 min; absorbance was measured at 700 nm. The standard curve was obtained using various concentrations of quercitin.
Antioxidant activity using 1,1-diphenyl-2-picrylhydrazyl (DPPH) assay
The estimation of the antioxidant activity was based on reduction of DPPH, a stable free radical. The experiment was conducted using the protocol of Xing et al. (2015). The cell free extracts of freshly-grown AF7 culture (of log phase with OD610 = 0.1) were obtained by centrifugation at 10,000 rpm for 5 min at 4 °C and 1 ml of the supernatant was added to 1 ml of 0.2 mM of DPPH solution (in methanol). The mixture was shaken and left to react for 30 min in the dark at room temperature. Deionized water was used as control. Absorbance was measured at 517 nm using Thermo Scientific™ Evolution 201 UV–Vis spectrophotometer and radical scavenging activity was calculated using the formula:
where ‘A control’ is the absorbance of the control, ‘A sample’ is the absorbance of sample.
Hydrogen peroxide scavenging activity
The hydrogen peroxide radicals scavenging activity of bacteria generated during salinity stress was determined by modifying the protocol of Ngonda (2013). Solution of 40 mM H2O2 was prepared in phosphate buffer (pH 7.4). Supernatant obtained from log phase bacterial culture (1 ml; with OD610 = 0.1) (grown at various salt concentrations) was added to H2O2 and incubated for 1 h at 37 °C. Absorbance was measured at 560 nm against phosphate buffer blank and percent of scavenging activity was calculated using the formula:
Pot experiment
Pot experiment was conducted in triplicates in earthen pots sized 15 × 11 × 11 cm during the months of July–September for two consecutive years (2017 and 2018). Saline soil (EC 9.2 dS/m) was collected from adjoining areas of Lucknow, Uttar Pradesh, India (26° 72 E, 80° 85 N). The pots were filled with 4 kg autoclaved and non-autoclaved saline soil without addition of fertilizers. Each treatment had three replicates which were arranged randomly in three blocks. The pots were grown in open greenhouse (Inostroza et al. 2016) and maximum, minimum temperature range during the 2 years was 37 °C, 24 °C in 2017 and 38 °C and 23 °C in 2018, respectively, with average humidity of about 75%. Prior to sowing, the soil was wetted properly and later irrigation was done twice daily with normal water. The physico-chemical properties of the soil including pH, EC, available nitrogen, phosphorous, potassium, organic carbon, organic matter, microbial biomass were checked according to the standard methods of Jackson (1973). Prior to pot experiment water agar plate assay was conducted to check the tolerance level of the rice variety (Moti Gold–NP 1024, from Nuziveedu seeds Ltd., Lucknow). The variety was selected, because farmers of the region commonly use it for rice cultivation (Dar et al. 2020). Seedlings (of Moti Gold-NP 1024) were found to grow up to EC 9 dS/m in lab conditions, but the growth reduced (in comparison to without salt conditions).Before sowing, rice seeds were surface sterilized using 3% hydrogen peroxide solution (Bakhsh et al. 2016). Talc-based bioformulation was prepared using the standard method of Nandakumar et al. (2001). In brief, 1 kg talc powder was taken and pH was adjusted to neutral by adding CaCO3 at the rate of 15 g/kg talc. Carboxymethyl cellulose (CMC) (1 g) was added to the mixture to enhance the sticking property of the bioformulation. The mixture was then autoclaved for sterilization. Bacterial culture suspension was prepared by growing AF7 in NB and incubated in a rotary shaker at 150 rpm at 27 ± 2 °C. After growth, 450 ml of log phase cell suspension (OD610 adjusted to ~ 1) was added to the carrier-cellulose mixture. To measure the population density, 1 g of bioformulation was added to 10 ml of distilled water and serially diluted to 10–6 and 10–7 (Tewari and Arora 2016). The bacterial density was found to be 4 × 108 CFU/g in the bioformulation. The sterilized seeds were dipped in the suspension of bioformulation, prepared at the rate of 20 g/L (Nandakumar et al. 2001) and left overnight for coating. Bacteria were found to be efficiently coated on seeds with population density 107 CFU/seed. For preparation of metabolite based formulation, EPS was dried and powdered and supplemented in various concentrations (0.1, 1.0, 2.0 and 5.0% weight/volume) to the bioformulation suspension. The combination of AF7 and 2% EPS was prepared by adding 20 mg EPS (w/v) to 1000 ml talc suspension containing AF7. Cell population of bacteria treated with bioformulation and EPS was found to be 107 CFU/seed. After soaking for 8–10 h (overnight) the seeds were dried for 2–3 h to adjust moisture content to ~ 35%. The seeds were then sowed in pots (15 seeds per pot) and thinning was performed after germination to 5 seeds per pot for homogeneity. The experiment was conducted in triplicates and treatments given were 0.1% EPS, 1.0% EPS, 2.0% EPS, 5.0% EPS, 2% EPS + AF7, 5% EPS + AF7 and untreated control. Plants were uprooted 60 days after sowing (DAS), and the effect of treatments on root length, shoot length, fresh weight and dry weight of the whole plant were analyzed.
The statistical analysis of the data was done using MS Excel, XLSTAT 2020 (Addinsoft 2020), and IBM SPSS Statistics 20. The relation between the variables was detected using Pearson correlation coefficient, the model significance was predicted using regression analysis, and analysis of variance (ANOVA) was done to compare the data using Duncan’s multiple range test (P < 0.05). Principal component analysis (PCA) was performed to compare PGP and salt tolerance properties of the isolate AF7 with different salinity levels. The correlation matrix based on Pearson method and matrix for coefficient of determination were drawn using XLSTAT to analyze the response model of bacteria against salinity.
Results and discussion
Isolation, identification and salt tolerance
In total twelve bacterial isolates were obtained from the saline soil of which AF7 was selected on the basis of significant salt tolerance and PGP properties under salt-stress conditions. Isolate AF7 was Gram negative, rod shaped, motile, showed production of ammonia, lipase, amylase, oxidase, catalase, citrate, and negative for urease, methyl red (MR) test, gelatinase, nitrate reductase, indole, cellulase, protease and H2S indicating it to be Alcaligenes sp. (Garrity 2005). Identification of AF7 by MALDI-TOF-MS Biotyper database concluded that the isolate best matched with Alcaligenes faecalis subsp. faecalis DSM 30030T with Biotyper score value of 2.254 (Supplementary Fig. 1). Furthermore, 16S rRNA sequence showed 99% similarity with Alcaligenes faecalis strain NBRC 13111 (Accession Number NR_113606.1) both through NCBI-BLASTn and Ez-Taxon (Supplementary Fig. 2). The gene sequence (1340 bp) of AF7 is submitted to NCBI GenBank with accession number MK898928. Alcaligenes AF7 was subsequently submitted to NAIMCC, India with accession number NAIMCC-B-02325.
The salinity tolerance assay showed that 300 mM NaCl did not significantly affect the growth of AF7. However, further increase in salt concentration reduced the tolerance and survival rate of bacteria. The doubling time of 240 min was found under non-saline conditions and 246 min at 300 mM NaCl, while 613 min was observed at 1400 mM NaCl (Supplementary Fig. 3). Comparing with earlier reports and criteria, isolate AF7 with ability to tolerate up to 1400 mM NaCl can be categorized as a halotolerant bacterium (Larsen (1986). Genus Alcaligenes has been previously reported with salt-tolerating ability. Behera et al. (2015) reported a halophilic strain A. faecalis D-TSB-1 which was able to tolerate 15% NaCl. Egamberdieva et al. (2019) reported salt tolerant A. faecalis TSAU3 from rhizosphere of wheat growing in saline soil with EC value of 560 ± 61 ms m−1. Similarly, Bal et al. (2013) reported halotolerant Alcaligenes sp. strain from the coastal rice fields with soil EC 6.88 dS/m. However, earlier studies did not investigate the mechanisms behind salt tolerance and growth promotion by Alcaligenes strains.
Plant growth promoting properties
Qualitative and quantitative analysis of PGP properties confirmed AF7 as IAA, GA, EPS and siderophore producer along with the ability to solubilize P and Zn both under saline and non-saline conditions. According to Tewari and Arora (2016) the maintenance of bacterial population (even under salt stress) could be the important factor for exhibition of PGP properties at high salinity. The nutrient chelation property of AF7 including phosphate solubilization was maintained up to 300 mM NaCl and then declined (coefficient of determination R2 = 0.8). The availability of P to plants helps in root formation, protection against stresses, sugar accumulation, regulation of stomata, transpiration, seed germination, gain in plant biomass, water uptake and formation of adenosine triphosphate (ATP) (Prakash and Arora 2019). Maximum Zn solubilization was also reported at 300 mM NaCl with complete decline at 1400 mM salinity (R2 = 0.624) suggesting negative relation with salinity. The phytohormonal analysis of AF7 revealed the highest production of GA (349.78 ± 2.94 µg/ml) and IAA (36.41 ± 0.5 µg/ml) at 300 mM NaCl. The correlative analysis indicated positive relation (r) = 0.75 for GA up to 700 mM NaCl, while for IAA (r) ~ 1 only up to 300 mM NaCl. Similar model was shown by Amna et al. (2019), suggesting that increase in salinity enhanced phytohormone production by Bacillus sp. hypothesizing the involvement of metabolites in salt tolerance mechanism. Yousef (2018) also reported higher IAA production by Bacillus subtilis at 0.5% and 1% NaCl in comparison to non-saline control and concluded that culture conditions and substrate variations may modify IAA productivity level. Upadhyay et al. (2009) reported that salt-tolerant stains of Bacillus produced GA but higher salt concentrations (8% NaCl) inhibited the production. Contrary to this, AF7 was found to be an efficient GA producer and production was found even at 1400 mM NaCl. IAA is directly involved in development of roots and altering their structures for better adaptation (Abbas et al. 2018). Gibberellins are important for cell elongation and division, root, stem and leaf extension, seed germination or dormancy, fruit senescence and flowering (Miceli et al. 2019). Isolate AF7 also managed to produce siderophore up to 700 mM NaCl, but higher salinity inhibited the production. By producing siderophore PGP bacteria can help the plant in obtaining iron from the soil and simultaneously controlling the phytopathogens. Chelation of iron helps in regulating various metabolic processes in plants such as chlorophyll synthesis, electron transfer in photosynthetic and respiratory chain processes and also aids synthesis of DNA, RNA and their repair (Ferreira et al. 2019). Sayyed and Chincholkar (2009) reported A. faecalis as an efficient siderophore producer but under non-saline conditions.
Maximum EPS production was reported at 300 mM NaCl, increasing significantly in comparison to non-saline conditions (Table 1), while the lowest production of 0.5 ± 0.12 g/100 ml at 1400 mM. The coefficient of determination (R2) was equal to 0.164 and P value ~ 0.5 (Fig. 1) which suggests that no relation was established and further research is required to prove how salinity regulates EPS synthesis. The carbohydrate content of EPS increased in the same manner, and maximum amount of 956.27 ± 5.87 mg/g at 300 mM salinity (increasing from 846.53 ± 5.20 mg/gm at 0 mM NaCl) was reported. Further increase in salinity reduced the sugar content and minimum was found at 1400 mM NaCl (331.33 ± 2.04 mg/gm). Confirming the concept that EPS production is the most important and primary response of bacteria against salinity stress (Khan et al. 2019), the present study illustrated that there was approximately threefold increase in production from non-saline condition to 300 mM salinity. Fathalla (2018) explained that under non-saline conditions, EPS production was reduced and then increased with salinity. It has been reported that in some PGPB, particularly those obtained from saline soils, production of EPS increases up to certain levels of salinity, suggesting its role in cell protection (Egamberdieva et al. 2019). Dixit et al. (2020) found IAA production of 3.09 µg/ml, P-solubilization index 1.8, EPS production 0.042 gm/100 ml and no siderophore production by alkalotolerant A. faecalis NBRI NB2.5. Isolate AF7 proved to be much better in all these PGP activities in comparison to its near relative A. faecalis NBRI NB2.5. Interestingly, A. faecalis NBRI NB2.5 was also found to be closely associated (99%) with Alcaligenes faecalis NBRC 13111T (just as AF7), which possibly hints about closeness in terms of PGP characteristics. Akintokun et al. (2019) showed GA production of 97.40 µg/ml by A. faecalis MY19 strain, which is again lesser than that produced by AF7.
Determination of the relationship between salinity, plant growth promotion and salt tolerance traits of Alcaligenes AF7 based on Pearson’s correlation of coefficient (P < 0.05) (a) image of the correlation matrix (b) image of the matrix of coefficients of determination (R2). IAA IAA production, GA gibberellic acid production, siderophore— siderophore production, EPS exopolysaccharide production, P phosphate solubilization, Zn zinc solubilization, proline— proline accumulation, sodium— sodium solubilization, antioxidant— antioxidation activity, hydroxyl— hydroxyl scavenging activity, reducing P— reducing power
Salt tolerance properties of the isolate
The onset of salinity stress invokes various synergistic mechanisms in bacteria including osmolyte accumulation, mitigation of ROS through antioxidant systems, ion homeostasis and EPS production which thereby help in the survival and protection against hyperosmotic surroundings (Pan et al. 2019; Arora et al. 2020). Therefore, the exact mechanisms of salt tolerance in AF7 were determined and correlated with salinity gradients. The most important concept of salinity amelioration involves the decreased uptake of Na+ by plants and regulating osmotic homeostasis to deduce the chances of flaccidity and death (Isayenkov and Maathuis 2019). The amount of sodium accumulated in AF7 cells increased from 4292.21 µg/gm of cell dry weight in control to 34,024.57 µg/gm of cell dry weight at 1000 mM NaCl. However, at 1400 mM NaCl the sodium content decreased (26,465.53 µg/gm of cell dry weight) which may be, because the growth was much reduced. The exponential increase in sodium influx was found to be related with salinity (correlation coefficient r = 0.86, up to 1400 mM NaCl level, Fig. 1) and the results are reflecting the direct conversation between bacteria and hyperosmotic surrounding. Assaha et al. (2017) reported that although high level of intracellular Na+ is toxic for bacterial cells but the counter mechanisms involve creation of many vacuolar structures for influx of cytoplasmic sodium ion through different porters. Also intracellular sodium ions are compensated by increased synthesis of osmolytes such as proline and glycine betaine which thereby balance the osmotic difference (Weinisch et al. 2018). Our results are in accordance with the study of Giri et al. (2013) which also reported enhanced intracellular Na+ concentration in Methylophilus sp. and Methylobacterium sp under salt stress. Proline is primarily involved in osmotic balancing, hydroxyl radical scavenging, reduced enzymatic inactivation, while in the second phase (when stress is relieved), proline can be degraded to provide energy to the plant/ microbe for driving essential metabolic activities (Wang et al. 2018). Alcaligenes sp. AF7 showed proline accumulation at all salt levels (up to 1400 mM) and there was 76% increase from non-saline conditions to 300 mM salinity and approximately 139% increase up to 1400 mM NaCl. The coefficient of regression (R2) = 0.86 and correlation coefficient (r) = 0.93 showed that there is a positive relationship between salinity and proline accumulation. Antioxidant activity is another essential biochemical marker of stress tolerance important for scavenging the ROS and reducing the cellular damage (Amna et al. 2019). The reducing power illustrated in the study indicates the potential antioxidant activity of isolate (Bhalodia et al. 2013). Based on absorbance and comparison with standard, reducing power was found maximum at 300 mM NaCl (Table 1), maintained significantly up to 1000 mM and was least at 1400 mM salinity (2.57 ± 0.19 mg/ml equivalent quercitin). The coefficient of regression (R2) was equivalent to 0.61, correlation coefficient (r) almost equal to 1 was reported up to 300 mM salinity, while an inverse correlation coefficient (r) = − 0.978 was observed for higher salinity (700–1400 mM). Explaining the DPPH assay, the increase in antioxidant property of AF7 was significant with the increase in salinity (P = 0.01) with a positive correlation (r = 0.96), the model of relativity was also proved with coefficient of regression (R2) equivalent to 0.92 (Fig. 1, Fig. 2). Similar trend was reported for hydroxyl scavenging potential of AF7 with coefficient of regression (R2) as 0.91 (shown in Fig. 1, Fig. 2) and correlation coefficient (r) equal to 0.95, relating the positive relation between salinity and ion scavenging activity of Alcaligenes sp. AF7. Durán et al. (2019) also found ROS scavenging enzymes, hydrogen peroxide mitigating systems and high halotolerance in Alcaligenes aquatilis strains under chemical and salinity stress. Mukherjee et al. (2019) reported that EPS also regulate the production or uptake of proline and accumulation of sodium ions. Interestingly, in the present study positive r value of 0.95 and 0.89 was found for EPS and proline, and EPS and Na+ accumulation, respectively, up to 700 mM NaCl concentration proving the hypothesis.
Principal component analysis (PCA) of PGP and salt tolerance traits of AF7
Results of PGP and salt tolerance traits versus salinity were analyzed through PCA. Considering the PGP characteristics, it was found that Principal component 1 (PC1) and Principal component 2 (PC2) accounted for 87.69% and 10.78% data variability, respectively (Fig. 3a). The comparative analysis showed that PGP properties including Zn solubilization, IAA, GA and EPS production were positively associated with 0–700 mM NaCl. The properties were increasing from non-saline to 300 mM NaCl conditions and were maintained up to 700 mM (Table 1). PCA of salt tolerance properties showed very interesting results which defined the response of bacteria at different salt conditions. PC1 and PC2 accounted for 84.01% and 10.75% variability, respectively. The distribution in the biplot revealed that salinity gradients (300–1400 mM NaCl) were in the positive direction, while non-saline (0 mM) in negative coordinate (Fig. 3b). The stress mitigation responses (proline and sodium accumulation, antioxidant and hydroxyl scavenging activity) were more at 1000–1400 mM NaCl. Thus, from the mathematical model it can be summarized that at lower levels of salinity (i.e., up to 300 mM NaCl) PGP properties were dominant, while at higher (i.e., above 700 mM NaCl) the stress adaption and survival responses were prominent (Table 1). A hypothesis can be drawn from this; properties which are showing highest increase are the immediate and most dominant response of bacteria to salinity. Among the PGP properties EPS was found to be the highest contributor followed by GA production. Proline accumulation was the primary tolerance response of bacteria against increasing salinity.
Estimating primary and dominant plant growth promoting (a) and salt-tolerance responses (b) of Alcaligenes AF7 under various saline conditions through Pearson coefficient based principal component analysis (P < 0.05). Variables designated as: Zn zinc solubilization, IAA indole acetic acid production, GA gibberellic acid production, EPS exopolysaccharide production, DPPH antioxidant activity
Pot experiment
The hypothesis established from the model was analyzed through pot trials on rice in both sterilized and non-sterilized saline soils. Effect of AF7 and EPS was checked on non-sterilized saline soil to replicate the conditions of field (in vivo conditions). The soil used for pot trial was saline with EC of 9.2 dS/m, pH 8.1, organic carbon content 3.3 gm/kg, available nitrogen 0.15 gm/kg, available phosphorous 41.3 mg/kg, available potassium 156 mg/kg, soil organic matter 5.7 gm/kg and microbial biomass 103.5 mg/kg. In sterilized soil, maximum increase in root length (160%), shoot length (114%), fresh weight (135%) and dry weight (93%) was reported for plants treated with 2% EPS and AF7 in respect to untreated control. Similar, trend of plant growth promotion was also found in non-sterilized soil, where 2% EPS and AF7 combination caused highest growth enhancement (Table 2). Results of 5% EPS plus AF7 were significantly similar (to 2% EPS plus AF7) hence not provided. Obviously 2% EPS amendment will also be more economical in comparison to 5%. Although application of AF7 also enhanced the growth parameters but were significantly lower in comparison to EPS plus AF7. The potential of AF7 to produce IAA, GA, EPS and chelate nutrients such as P, Zn, Fe even in saline conditions could be the possible reason for growth promotion of rice. The stress resilience in plants inoculated with AF7 could be possibly due to the tendency of bacteria to accumulate osmolytes, presence of antioxidant systems and reduction potential. Yang et al. (2009) showed that the presence of these ST traits elicited “Induced Systemic Tolerance” in plants. Addition of EPS in the bioinoculant provided added advantages as it can protect bacteria against the aftershocks upon soil application and establish a stable population of microbes, along with availability of nutrients and water through biofilm formation on the root surface (Sandhya and Ali 2015). Arora and Mishra (2016) discussed about the importance of additives like EPS in bioformulation to achieve better results and also to increase the shelf life and effectiveness of the inoculant. The inoculation of EPS is also reported in enhancing soil conditioning effects including trapping of Na+ from soil, improve soil structure by chelation of nutrients, formation of soil aggregates and increasing water holding capacity (Ding et al. 2018). Boukhelata et al. (2018) reported that EPS produced by Alcaligenes latus can absorb 1000 times more water than its dry weight. This study is in lineation with the results obtained by Tewari and Sharma (2020) reporting growth promotion of Cajanus cajan upon inoculation with rhizobia and EPS under abiotic stresses. Similarly, Meneses et al. (2011) concluded that EPS production is important for colonization and root attachment of Gluconacetobacter diazotrophicus PAL5 in rice. Apart from bacterial cell protection against stress, EPS is also reported to enhance Zn and phosphate-solubilizing activity of microbes (Yi et al. 2008; Morillo Pérez et al. 2008). Interestingly, Donati et al. (2013) reported that IAA induces EPS production and biofilm formation. Hence, the mutualistic relationship between the metabolite and bacteria could have acted synergistically with multiphasic roles enhancing the growth parameters of plants under salinity stress.
There are very few reports on utilization of Alcaligenes strains for plant growth promotion under salinity stress. Ibal et al. (2018) utilized Alcaligenes defragans for improving the health of plants and remediating the soil. Omer (2017) reported salt-tolerant strain of A. faecalis capable of tolerating 7% NaCl and showing the enhancement of wheat growth under 1% NaCl stress. Timmusk et al. (2018) showed growth promotion of wheat under salt and drought stress upon inoculation with A. faecalis AF. However, role and ability of PGPB strains of Alcaligenes in saline environment is not much known. The study through statistical analysis suggests the role of PGP attributes and salt stress adaptation strategies for an Alcaligenes sp. The study also proves a novel approach, where a PGP Alcaligenes isolate based bioinoculant along with its metabolite (EPS) is being reported to enhance the growth of rice under salt stress. However, future field studies can provide deeper insights into the effects triggered in plants treated with the novel bioformulation when grown in saline fields.
Conclusion
It can be concluded from the study that salinity induces various responses in microbes to mitigate the abiotic stress. In the present study Alcaligenes sp. is reported as an efficient ST-PGPB with stress mitigating properties even at 1400 mM salt level. The production of EPS under increasing salinity was observed as the most prominent PGP trait. The study through statistical model explains the mechanism of action of Alcaligenes sp. AF7 at increasing levels of salts. The model highlights that at lower salt levels AF7 primarily produces metabolites involved in plant growth promotion, while at further increase in salinity, survival becomes more important. The application of bioinoculant of Alcaligenes sp. amended with EPS in saline conditions showed maximum increase in growth parameters of rice. The results proved that EPS along with PGPB can be a promising eco-friendly and cost-effective approach for stimulating the growth of plants under salt-stressed conditions.
References
Abbas M, Hernández-García J, Pollmann S, Samodelov SL, Kolb M, Friml J, Alabadí D (2018) Auxin methylation is required for differential growth in Arabidopsis. Proc Natl Acad Sci 115(26):6864–6869
Addinsoft (2020) XLSTAT statistical and data analysis solution. New York, USA. https://www.xlstat.com
Ahmad F, Ahmad I, Khan MS (2008) Screening of free-living rhizospheric bacteria for their multiple plant growth promoting activities. Microbiol Res 163(2):173–181
Akintokun AK, Ezaka E, Akintokun PO, Shittu OB, Taiwo LB (2019) Isolation, screening and response of maize to plant growth promoting rhizobacteria inoculants. Sci Agric bohem 50(3):181–190
Altschul FS, Warren G, Miller W, Myers EW, Lipman DJ (1990) Basic local alignment search tool. J Mol Biol 215:403–410
Amna BUD, Sarfraz B, Xia Y, Kamran MA, Javed MT, Sultan T, Munis MFH, Chaudhary HJ (2019) Mechanistic elucidation of germination potential and growth of wheat inoculated with exopolysaccharide and ACC-deaminase producing Bacillus strains under induced salinity stress. Ecotoxicol Environ Saf 183:109466
Arora NK, Fatima T, Mishra I, Verma M, Mishra J, Mishra V (2018) Environmental sustainability: challenges and viable solutions. Environ Sustain 1(4):309–340
Arora NK, Mishra J (2016) Prospecting the roles of metabolites and additives in future bioformulations for sustainable agriculture. Appl Soil Ecol 107:405–407
Arora NK, Verma M (2017) Modified microplate method for rapid and efficient estimation of siderophore produced by bacteria. 3 Biotech 7(381):1–9
Arora NK, Fatima T, Mishra J, Mishra I, Verma S, Verma R, Verma M, Bhattacharya A, Verma P, Mishra P, Bharti C (2020) Halo-tolerant plant growth promoting rhizobacteria for improving productivity and remediation of saline soils. J Adv Res. https://doi.org/10.1016/j.jare.2020.07.003
Assaha DVM, Ueda A, Saneoka H, Al-Yahyai R, Yaish MW (2017) The role of Na+ and K+ transporters in salt stress adaptation in glycophytes. Front Physiol 18:509
Bakhsh K, Akram W, Jahanzeb A, Khan M (2016) Estimating productivity of Bt cotton and its impact on pesticide use in Punjab, Pakistan. Pak Econ Soc Rev 54(1):15–24
Bal HB, Nayak L, Das S, Adhya TK (2013) Isolation of ACC deaminase PGPR from rice rhizosphere and evaluating their plant growth promoting activity under salt stress. Plant Soil 366:93–105
Bargaz A, Lyamlouli K, Chtouki M, Zeroual Y, Dhiba D (2018) Soil microbial resources for improving fertilizers efficiency in an integrated plant nutrient management system. Front Microbiol 9:1606
Bates L, Waldren RP, Teare ID (1973) Rapid determination of free proline for water-stress studies. Plant Soil 39:205–207
Behera BK, Das P, Maharana J, Meena DK, Sahu TK, Rao AR, Chatterjee S, Mohanty BP, Sharma AP (2015) Functional screening and molecular characterization of halophilic and halotolerant bacteria by 16S rRNA gene sequence analysis. Proc Natl Acad Sci India B Biol Sci 85:957–964
Bhalodia NR, Nariya PB, Acharya RN, Shukla VJ (2013) In vitro antioxidant activity of hydro alcoholic extract from the fruit pulp of Cassia fistula Linn. Ayu 34:209–214
Boukhelata N, Taguett F, Kaci Y (0201M) Characterization of an extracellular polysaccharide produced by Saharan bacterium Paenibacillus tarimensis REG 0201M. Ann Microbiol 69:93–106
Bradford MM (1976) A rapid and sensitive method for the quantitation of microgram quantities of protein utilizing the principle of protein-dye binding. Anal Biochem 72:248–254
Dar MH, Waza SA, Shukla S, Zaidi NW, Nayak S, Hossain M, Kumar A, Ismail AM, Singh US (2020) Drought tolerant rice for ensuring food security in Eastern India. Sustainability 12:2214
Ding P, Song W, Yang Z, Jian J (2018) Influence of Zn(II) stress-induction on component variation and sorption performance of extracellular polymeric substances (EPS) from Bacillus vallismortis. Bioprocess Biosyst Eng 41:781–791
Dixit VK, Misra S, Mishra SK, Joshi N, Chauhan PS (2020) Characterization of plant growth-promoting alkalotolerant Alcaligenes and Bacillus strains for mitigating the alkaline stress in Zea mays. Antonie Van Leeuwenhoek 113:889–905
Donati AJ, Lee HI, Leveau JH, Chang WS (2013) Effects of indole -3-acetic acid on the transcriptional activities and stress tolerance of Bradyrhizobium japonicum. PLoS ONE 8:e76559
Dubois M, Gilles K, Hamilton J, Rebers P, Smith F (1956) Colorimetric method for determination of sugars and related substances. Anal Chem 28:350–356
Durán RE, Barra-Sanhuez B, Salvà-Serra F, Méndez V, Jaén-Luchoro D, Moore ERB, Seeger M (2019) Complete genome sequence of the marine hydrocarbon degrader Alcaligenes aquatilis QD168, isolated from crude oil-polluted sediment of Quintero Bay, Central Chile. Microbiol Resour Announc 8:e01664–e1718
Egamberdieva D, Wirth S, Bellingrath-Kimura SD, Mishra J, Arora NK (2019) Salt-tolerant plant growth promoting rhizobacteria for enhancing crop productivity of saline soils. Front Microbiol 10:2791
Etesami H, Glick BR (2020) Halotolerant plant growth–promoting bacteria: prospects for alleviating salinity stress in plants. Environ Exp Bot. https://doi.org/10.1016/j.envexpbot.2020.104124
FAO (2015) Global soil partnership- world soil charter. https://www.fao.org/3/a-mn442e.pdf
Fasim F, Ahmed N, Parsons R, Gadd GM (2002) Solubilization of zinc salts by a bacterium isolated from the air environment of a tannery. FEMS Microbiol Lett 213:1–6
Fathalla AM (2018) Effectiveness of exopolysaccharides and biofilm forming plant growth promoting rhizobacteria on salinity tolerance of faba bean (Vicia faba L.). Afr J Microbiol Res 12:399–404
Fatima T, Arora NK (2019) Plant growth-promoting rhizospheric microbes for remediation of saline soils. In: Arora NK, Kumar N (eds) Phyto and Rhizo Remediation. Springer, Singapore, pp 121–146
Ferreira MJ, Silva H, Cunha A (2019) Siderophore producing rhizobacteria as a promising tool for empowering plants to cope with iron limitation in saline soils: a review. Pedosphere 29(4):409–420
Garrity G (2005) The proteobacteria, Part B the gammaproteobacteria. In: Garrity G, Brenner DJ, Krieg NR, Staley JR (eds) Bergey’s manual of systematic bacteriology, vol 2. Springer, New York, pp 323–337
Ghosh B, Ali MN, Saikat G (2016) Response of rice under salinity stress: a review update. J Res Rice 4:167
Giri DD, Kumar A, Shukla PN, Singh R, Singh PK, Pandey KD (2013) Salt stress tolerance of methylotrophic bacteria Methylophilus sp. and Methylobacterium sp. isolated from coal mine spoils. Pol J Microbiol 62(3):273–280
Hoang TM, Tran TN, Nguyen TK, Williams B, Wurm P, Bellairs S, Mundree S (2016) Improvement of salinity stress tolerance in rice: challenges and opportunities. Agronomy 6:54
Ibal JC, Jung BK, Park CE, Shin JH (2018) Plant growth-promoting rhizobacteria used in South Korea. Appl Biol Chem. https://doi.org/10.1007/s13765-018-0406-0
Inostroza NG, Barra PJ, Wick LY, Mora ML, Jorquera MA (2016) Effect of rhizobacterial consortia from undisturbed arid- and agro-ecosystems on wheat growth under differing conditions. Lett Appl Microbiol 64:158–163
Isayenkov SV, Maathuis FJM (2019) Plant salinity stress: many unanswered questions remain. Front Plant Sci 10:80
Jackson ML (1973) Soil chemical analysis. Prentice Hall of India Pvt. Ltd., New Delhi, pp 38–56
Khan N, Bano A, Rahman MA, Guo J, Kang Z, Babar MA (2019) Comparative physiological and metabolic analysis reveals a complex mechanism involved in drought tolerance in chickpea (Cicer arietinum l.) induced by PGPR and PGRs. Sci Rep 9:2097
Khare E, Singh S, Maheshwari DK, Arora NK (2011) Suppression of charcoal rot of chickpea by fluorescent Pseudomonas under saline stress condition. Curr Microbiol 62:1548–1553
Kumar S, Stecher G, Li M, Knyaz C, Tamura K (2018) MEGA X: molecular evolutionary genetics analysis across computing platforms. Mol Biol Evol 35:1547–1549
Larsen H (1986) Halophilic and halotolerant microorganisms- an overview and historical perspective. FEMS Microbiol Rev 39:3–7
Machado RMA, Serralheiro RP (2017) Soil salinity: effect on vegetable crop growth. Management practices to prevent and mitigate soil salinization. Horticulturae 3(2):30
Mendi A, Aslim B (2014) Antioxidant lactobacilli could protect gingival fibroblasts against hydrogen peroxide: a preliminary in vitro study. Probiot Antimicrob Proteins 6:157–164
Meneses CHSG, Rouws LFM, Araújo JLS, Vidal MS, Baldani JI (2011) Exopolysaccharide production is required for biofilm formation and plant colonization by the nitrogen-fixing endophyte Gluconacetobacter diazotrophicus. Mol Plant Microbe Interact 24(12):1448–1458
Miceli A, Vetrano F, Sabatino L, D’Anna F, Moncada A (2019) Influence of preharvest gibberellic acid treatments on postharvest quality of minimally processed leaf lettuce and rocket. Horticulturae 5:63
Mody B, Bindra M, Modi V (1989) Extracellular polysaccharides of cowpeas rhizobia; compositional and functional studies. Arch Microbiol 153:33–42
Morillo Pérez JA, García-Ribera R, Quesada T, Aguilera M, Ramos-Cormenzana A, Monteoliva-Sánchez M (2008) Biosorption of heavy metals by the exopolysaccharide produced by Paenibacillus jamilae. World J Microbiol Biotechnol 24:2699
Mukherjee P, Mitra A, Roy M (2019) Halomonas rhizobacteria of Avicennia marina of Indian Sundarbans promote rice growth under saline and heavy metal stresses through exopolysaccharide production. Front Microbiol 10:1207
Munns R, Tester M (2008) Mechanisms of salinity tolerance. Ann Rev Plant Biol 59:651–681
Nandakumar R, Babu S, Viswanathan R, Sheela J, Raguchander T, Samiyappan R (2001) A new bio-formulation containing plant growth promoting rhizobacterial mixture for the management of sheath blight and enhanced grain yield in rice. Biocontrol 46:493–510
Ngonda F (2013) In vitro anti-oxidant activity and free radical scavenging potential of roots of Malawian Trichodesma zeylanicumm (burm. f.). Asian J Biomed Pharma Sci 3(20):21–25
Omer AM (2017) Inducing plant resistance against salinity using some rhizobacteria. Egypt J Desert Res 67(1):185–206
Orhan F (2016) Alleviation of salt stress by halotolerant and halophilic plant growth-promoting bacteria in wheat (Triticum aestivum). Braz J Microbiol 47:621–627
Osman KT (2018) Saline and sodic soils. In: Osman KT (ed) Management of soil problems. Springer, Cham, pp 255–298
Paleg LG (1965) Physiological effects of gibberellins. Ann Rev Plant Physiol 16:291–322
Pan J, Peng F, Xue X, You Q, Zhang W, Wang T, Huang C (2019) The growth promotion of two salt-tolerant plant groups with PGPR inoculation: a meta-analysis. Sustainability 11:378
Pikovskaya RI (1948) Mobilization of phosphorus in soil connection with the vital activity of some microbial species. Microbiology 17:362–370
Prakash J, Arora NK (2019) Phosphate-solubilizing Bacillus sp. enhances growth, phosphorus uptake and oil yield of Mentha arvensis L. 3 Biotech 9(4):126
Rahi P, Prakash O, Shouche YS (2016) Matrix assisted laser desorption/ionization time-of-flight mass-spectrometry (MALDI-TOF MS) based microbial identifications: challenges and scopes for microbial ecologists. Front Microbiol 7:1359
Rahneshan Z, Nasibi F, Moghadam AA (2018) Effects of salinity stress on some growth, physiological, biochemical parameters and nutrients in two pistachio (Pistacia vera L.) rootstocks. J Plant Interact 13(1):73–82
Rodriguez PA, Rothballer M, Chowdhury SP, Nussbaumer T, Gutjahr C, Falter-Braun P (2019) Systems biology of plant-microbiome interactions. Mol Plant 12:804–821
Saitou N, Nei M (1987) The neighbor-joining method: a new method for reconstructing phylogenetic trees. Mol Biol Evol 4:406–425
Sandhya V, Ali SZ (2015) The production of exopolysaccharide by Pseudomonas putida gap_p45 under various abiotic stress conditions and its role in soil aggregation. Microbiology 84:512–519
Sayyed RZ, Chincholkar SB (2009) Siderophore-producing Alcaligenes feacalis exhibited more biocontrol potential Vis-a`-Vis chemical fungicide. Curr Microbiol 58:47–51
Schwyn B, Neilands JB (1987) Universal chemical assay for the detection and determination of siderophores. Anal Biochem 160:47–56
Shahid SA, Zaman M, Heng L (2018) Soil salinity: historical perspectives and a world overview of the problem. In: Zaman M, Shahid S, Heng L (eds) Guideline for salinity assessment, mitigation and adaptation using nuclear and related techniques. Springer, Cham, pp 43–53
Srinivasan R, Karaoz U, Volegova M, MacKichan J, Kato-Maeda M, Miller S, Nadarajan R, Brodie EL, Lynch SV (2015) Use of 16S rRNA gene for identification of a broad range of clinically relevant bacterial pathogens. PLoS ONE 10:e0117617
Tewari S, Arora NK (2016) Fluorescent Pseudomonas sp. PF17 as an efficient plant growth regulator and biocontrol agent for sunflower crop under saline conditions. Symbiosis 68(1–3):99–108
Tewari S, Sharma S (2020) Rhizobial exopolysaccharides as supplement for enhancing nodulation and growth attributes of Cajanus cajan under multi-stress conditions: a study from lab to field. Soil Till Res 198:104545
Timmusk S, Seisenbaeva G, Behers L (2018) Titania (TiO2) nanoparticles enhance the performance of growth-promoting rhizobacteria. Sci Rep 8:617
Umali DL (1993) Irrigation induced salinity: a growing problem for development and the environment (English). World Bank technical paper; no. WTP 215. Washington, DC: TheWorld Bank
Upadhyay SK, Singh DP, Saikia R (2009) Genetic diversity of plant growth promoting rhizobacteria from rhizospheric soil of wheat under saline conditions. Curr Microbiol 59(5):489–496
Wang W, Wu Z, He Y, Huang Y, Li X, Ye B (2018) Plant growth promotion and alleviation of salinity stress in Capsicum annuum L. by Bacillus isolated from saline soil in Xinjiang. Ecotoxicol Environ Saf 164:520–529
WeinischKu¨hner LS, Roth R, Grimm M, Roth T, Netz DJA, Pierik AJ, Filker S (2018) Identification of osmoadaptive strategies in the halophile, heterotrophic ciliate Schmidingerothrix salinarum. PLoS Biol 16(1):e2003892
Xing J, Wang G, Zhang Q, Liu X, Gu Z, Zhang H, Chen YQ, Chen W (2015) Determining antioxidant activities of lactobacilli cell-free supernatants by cellular antioxidant assay: a comparison with traditional methods. PLoS ONE 10(3):e0119058
Yang J, Kloepper JW, Ryu CM (2009) Rhizosphere bacteria help plants tolerate abiotic stress. Trends Plant Sci 14:14
Yi Y, Huang W, Ge Y (2008) Exopolysaccharide: a novel important factor in the microbial dissolution of tricalcium phosphate. World J Microbiol Biotechnol 24:1059–1065
Yoon SH, Ha SM, Lim J, Kwon S, Chun J (2017) A large-scale evaluation of algorithms to calculate average nucleotide identity. Antonie Van Leeuwenhoek 110:1281–1286
Yousef NMH (2018) Capability of plant growth-promoting rhizobacteria (PGPR) for producing indole acetic acid (IAA) under extreme conditions. Eur J Biol Res 8:174–182
Zeigler RS, Barclay A (2008) The relevance of rice. Rice 1(1):3–10
Author information
Authors and Affiliations
Corresponding author
Ethics declarations
Conflict of interest
All authors declare that there is no conflict of interest in this original article.
Ethical approval
The study does not involve any work on humans or animals hence do not require any ethical clearance.
Electronic supplementary material
Below is the link to the electronic supplementary material.
Rights and permissions
About this article
Cite this article
Fatima, T., Mishra, I., Verma, R. et al. Mechanisms of halotolerant plant growth promoting Alcaligenes sp. involved in salt tolerance and enhancement of the growth of rice under salinity stress. 3 Biotech 10, 361 (2020). https://doi.org/10.1007/s13205-020-02348-5
Received:
Accepted:
Published:
DOI: https://doi.org/10.1007/s13205-020-02348-5